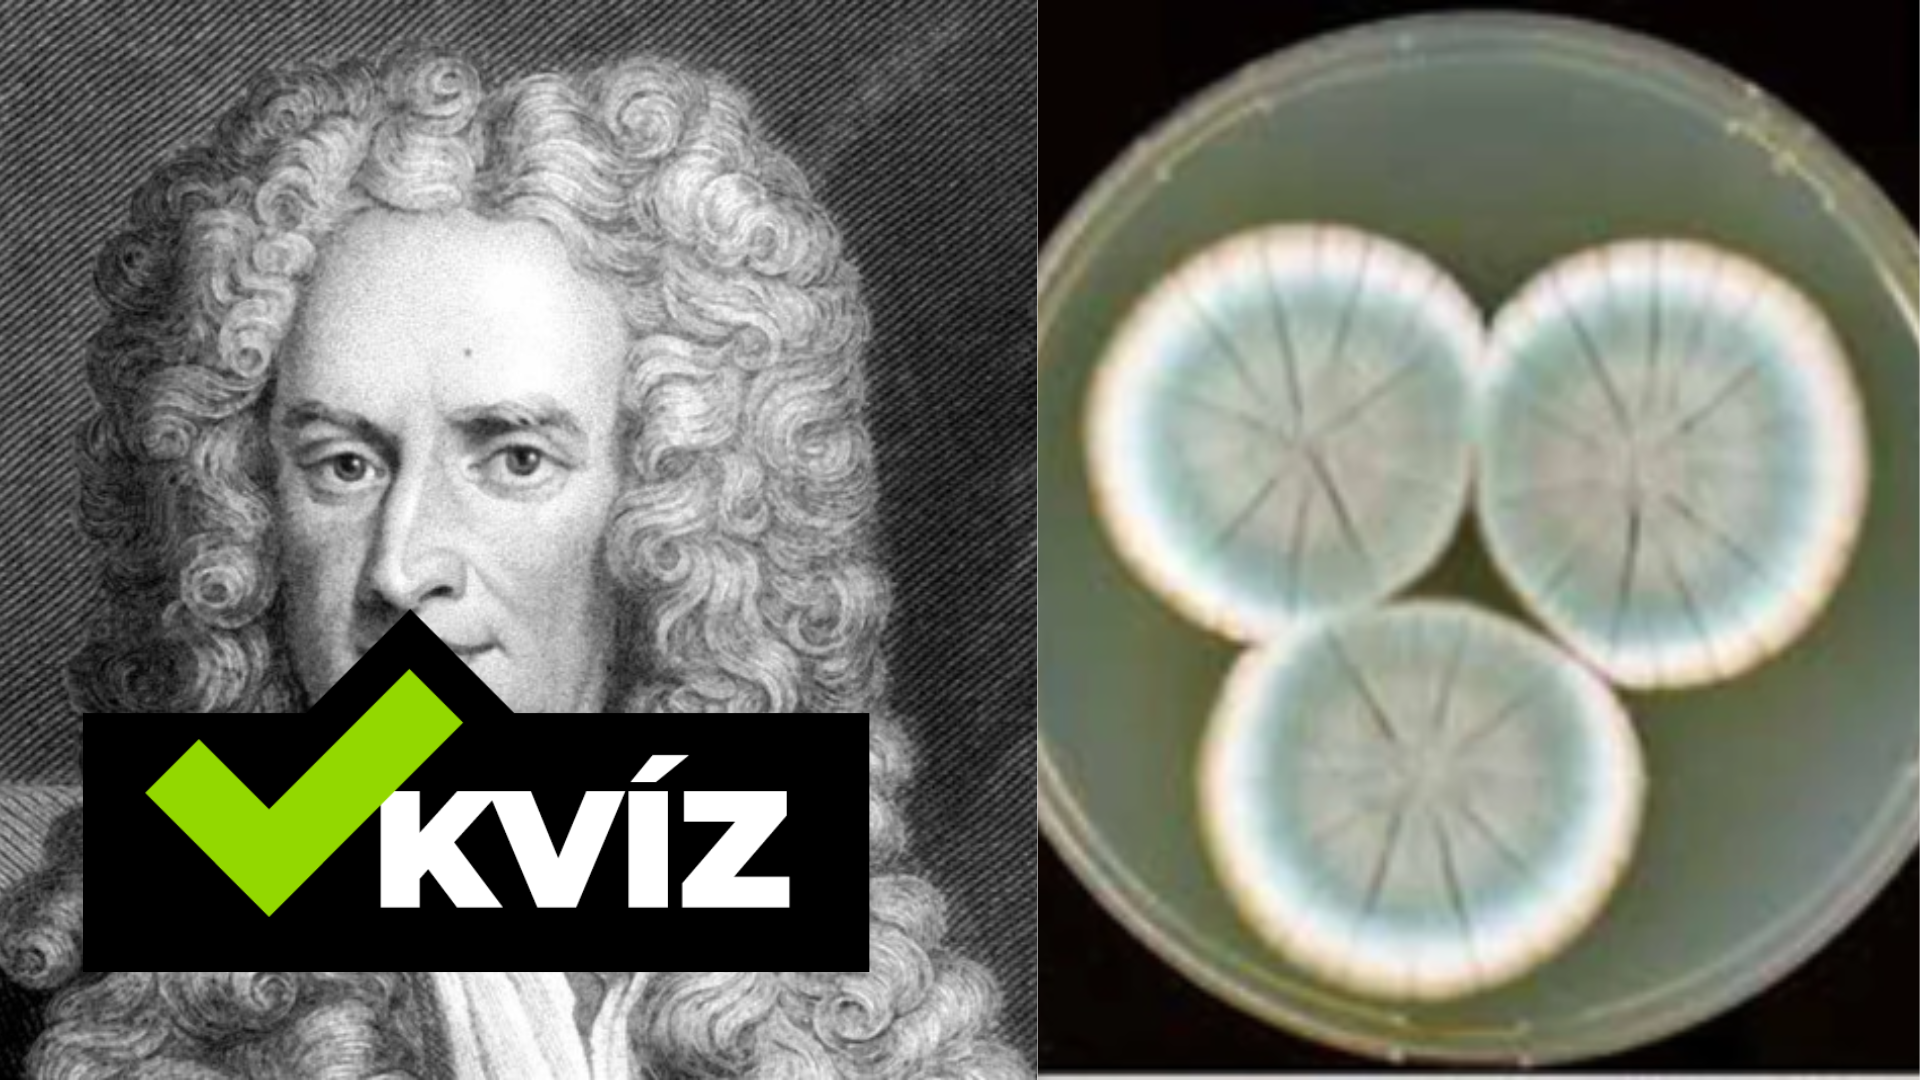
Isaac Newton, penicilín

TOP Vedecké objavy a vynálezy, ktoré zmenili svet. Tieto veci by si mal ovládať aj o polnoci
- Bez nich by svet vyzeral úplne odlišne
- Dokáž, že sa vyznáš vo významných vedeckých objavoch a vynálezoch
- Za niektorými stoja aj Slováci
Všetci sme sa o nich učili, no nie každý si ich pamätá. Na náš svet však mali zásadný vplyv a súčasnosť by bez nich vyzerala úplne inak. Reč je o slávnych vedeckých objavoch, vynálezoch a vynálezcoch. Základy vedy a histórie sa vyučujú už na základnej škole a mal by ich poznať každý z nás.
O Albertovi Einsteinovi, Teslovi, gravitácii či Nobelových cenách si už určite počul. Dokáž, že máš vedecké objavy a vynálezy v malíčku a nenecháš sa nachytať na tom, čo sme si pre teba pripravili.
Kto stojí za objavom penicilínu?
 Wikimedia: Cacyle
Wikimedia: Cacyle
Lekár Alexander Fleming si v roku 1928 na neumytých miskách s kultiváciami všimol plesne. Jedna miska bola zaujímavá tým, že v okolí plesne sa baktérie nenachádzali. Jav ho inšpiroval k pokusom s izolovaním protibakteriálnej látky, ktorú zjavne vylučovala pleseň Penicillium notatum. Nazval ju penicilín. Flemingov objav začal revolúciu v medicíne.
Vynález telefónu sa prisudzuje:
 Wikimedia
Wikimedia
Rodák zo škótskeho Edinburghu sa preslávil ako vynálezca telefónu a gramofónu.
V ktorom roku bola objavená gravitácia?
 Unsplash/Aarón Blanco Tejedor
Unsplash/Aarón Blanco Tejedor
Podľa legendy malo Newtonovi spadnúť na hlavu jablko, ktoré ho priviedlo k myšlienke, že telesá podliehajú pôsobeniu gravitácie – a zároveň sú aj zdrojom gravitačnej sily. Bližšie k pravde je však vysvetlenie, že vedca inšpiroval skôr pohľad na padajúce ovocie. Isac Newton vo svojom gravitačnom zákone v roku 1686 sformuloval gravitačné pôsobenie aj matematicky. Podľa neho je gravitačná sila priamo úmerná hmotnosti telies, ktoré sa priťahujú, a naopak, nepriamo úmerná ich vzdialenosti. Teda čím sú telesá od seba ďalej, tým sa priťahujú slabšie.
Čím sa preslávil mních Gregor Mendel?
 TASR
TASR
Augustiniánsky mních a kňaz, botanik a prírodovedec Johann Gregor Mendel je duchovným otcom novodobej náuky o dedičnosti.
Ktorý z týchto objavov nevykonal Nikola Tesla?
 Pixabay
Pixabay
Američan John Blankenbaker v roku 1970 vynašiel a v roku 1971 predal prvý osobný počítač na svete Kenbak-1.
Ktorý vedec ako jediný získal dve Nobelove ceny, o ktoré sa nemusel s nikým deliť? Za čo tieto Nobelove ceny dostal?
 TASR/AP
TASR/AP
Linus Pauling získal dve Nobelove ceny, ktoré však s nikým nezdieľal. Išlo o cenu za chémiu v roku 1954 za štúdium chemických väzieb a štruktúry molekúl a cenu za mier, ktorú získal v roku 1962 za boj proti nukleárnym zbraniam.
Slovensko má tiež svojich slávnych vynálezcov. Ktorý z nich vynašiel padák?
 Unsplash/Ricardo Gomez Angel
Unsplash/Ricardo Gomez Angel
Štefan Banič bol slovenský konštruktér a vynálezca, majiteľ amerického patentu na padák z roku 1914. Slávu ani peniaze mu však nepriniesol. Po návrate na Slovensko jeho meno zarezonovalo ešte raz, keď sa stal spoluobjaviteľom jaskyne Driny pri Smoleniciach.
Ktorý veľmi slávny vedec začínal ako úradník na patentovom úrade v Berne?
 Unsplash/Andreas Fischinger
Unsplash/Andreas Fischinger
V roku 1921 bola Einsteinovi za vysvetlenie fotoelektrického javu a zásluhy v oblasti teoretickej fyziky udelená Nobelova cena za fyziku. Na začiatku svojej kariéry však pôsobil ako expert 3. triedy na patentovom úrade v Berne
Za otca očkovania sa považuje:
 SITA/AP, Elias Funez
SITA/AP, Elias Funez
Zakladateľ mikrobiológie, lekárskej imunológie a stereochémie Louis Pasteur bol francúzsky chemik, biológ a lekár. K jeho objavom okrem iných patria očkovacie látky proti besnote a sneti slezinnej alebo antraxu.
Ako sa volá vynálezca na obrázku?
 TASR/AP
TASR/AP
Čítaj viac z kategórie: Zaujímavosti
Zdroje: TASR, SITA, Veda na dosah









